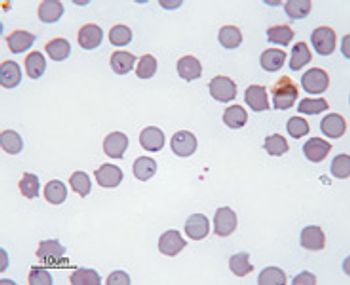

Adam Birkenheuer, DVM, PhD, DACVIM
Articles by Adam Birkenheuer, DVM, PhD, DACVIM

Dr. Adam Birkenheuer explains the relevance of Occam's razor when looking through your laboratory test results.From the CVC in San Diego, veterinary internist Dr. Adam Birkenheuer explains the relevance of Occam's razor when looking through your laboratory test results.

Dr. Adam Birkenheuer gives pointers to make sure you get the most out of your laboratory test results.You run and review the results of complete blood counts and serum chemistry profiles all the time. But important conclusions may elude you if you rush through your analysis. Here are a few common areas you might overlook.

In my opinion, the introduction of in-house enzyme-linked immunosorbant assays for infectious disease screening has been one of the most useful innovations in veterinary medicine. On occasion however it can create a mild "dilemma" for us as clinicians.

RMSF caused by Rickettsia rickettsii is an acute systemic disease of dogs and humans. RMSF is generally seasonal (Apr.-Sept.) correlating with the Dermacentor sp. lifecycle.

Leptospirosis is a zoonotic disease caused by bacteria in the genus Leptospira. The taxonomy of genus Leptospira is complex and continuing to evolve. Historically, there were only two recognized species, L. interrogans and L. biflexa, that were further divided into nearly 300 serovars.

Canine babesiosis was first described in South Africa in the late 1800's and was originally presumed to be a "biliary form" of canine distemper. Most researchers assume that this was actually a case of babesiosis caused by Babesia canis rossi.

Fever is defined as a higher than normal body temperature (>102.5) due to altered thermoregulatory mechanisms in the hypothalamus. Fever of unknown origin (FUO) is a fever that does not resolve spontaneously and for which no obvious cause is identified. Infectious disease, immune-mediated conditions and neoplasia account for over 75% of FUO cases.

Dogs with IMHA are usually older than 1 year of age. There does not appear to be a significant gender predisposition. Several breeds have a higher incidence of IMHA, such as cocker spaniels, miniature poodles, old English sheepdogs, and Doberman pinschers. Hereditary erythrocyte disease (PK and PFK deficiency osmotic fragility).

Cytauxzoonosis is a tick-transmitted protozoan disease of cats caused by Cytauxzoon felis that was first reported in Missouri in 1976. Over the next thirty years the disease was only recognized in the southcentral and southeastern United States. Recently the geographic range of the organism has been recognized to extend east and north.
Several vector-borne diseases in dogs and cats appear to be emerging in the United States, including babesiosis, cytauxzoonosis, bartonellosis, leishmaniasis, hepatozoonosis, and feline ehrlichiosis. This article focuses on babesiosis, cytauxzoonosis, and bartonellosis, which have been reported with increased frequency in the United States over the past decade.